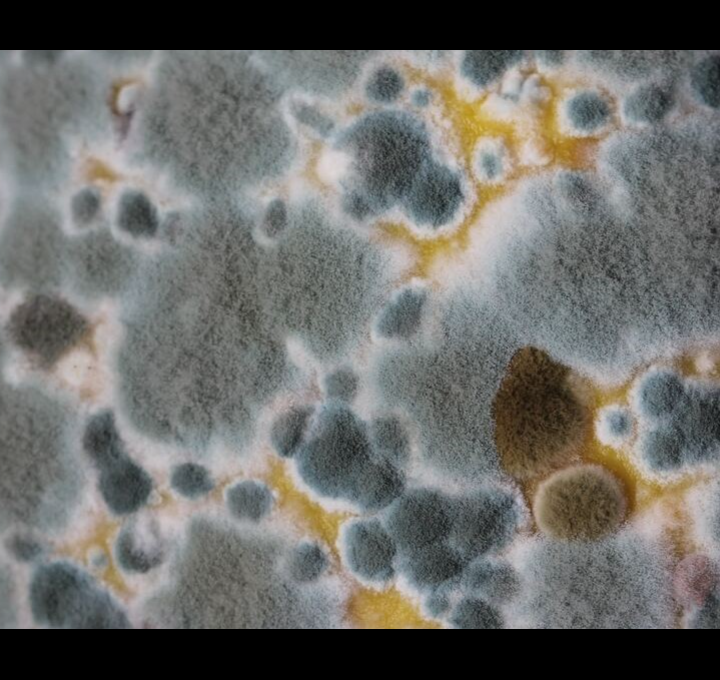

I miedzą, miedzą. Ni widu, ni kresu.
Mglisto i płasko do samych Skierniewic.
Mglisto i płasko dalej, do Uralu.
Ej, nie ustawaj, nieprędko południe.1
MGLISTO I PŁASKO
W dramacie Bowie w Warszawie bohaterem tytułowym jest muzyk David Bowie, który podróżuje pociągiem z Moskwy na Zachód i po drodze odwiedza Warszawę.